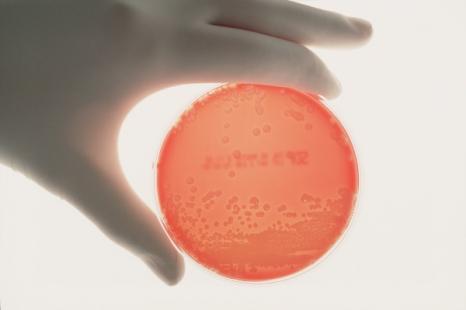

Selon le Centre européen de prévention et de contrôle des maladies (ECDC), la pandémie de Covid-19 aurait contribué à la multiplication des infections résistantes aux antimicrobiens au sein de l'Union Européenne.
Selon le rapport, plus de 35 000 personnes meurent chaque année d'infections dues à des agents pathogènes résistants aux antibiotiques, appelés « superbactéries ». Des chiffres en hausse depuis 2020, et plus particulièrement en 2021.

À la Une
Malgré la hausse du Smic, statu quo sur les salaires
Rapport Charges et produits 2027
Vaccination pneumocoque : l’assurance-maladie plaide pour une campagne nationale
Émergence de dermatose
Dermatophilus : le ministère de la Santé appelle à la vigilance
Contraception et prévention des IST
Les préservatifs masculins en latex Soft remboursables